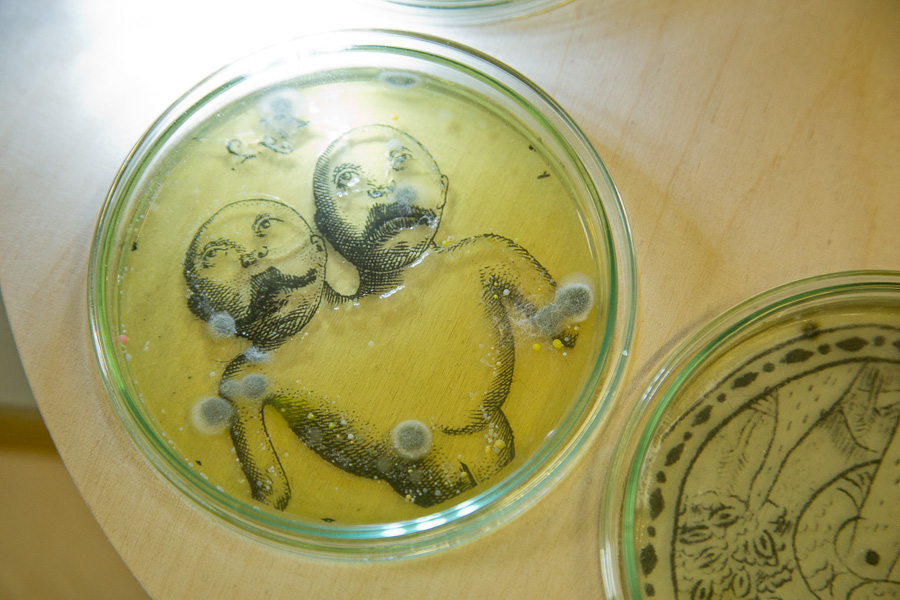

Colonies. Cultivo de bacterias, microscópio USB, base giratoria, proyección HD. Bilbao - 2016

Intervención sobre imágenes mediante varios cultivos de bacterias. Una proyección retransmite en tiempo real las images amplificadas de los trazos de los dibujos y los microorganismos, mientras una base giratoria rota los cultivos muy lentamente.
Los cultivos de bacterias crecen permanentemente colonizando el espacio de la imagen.